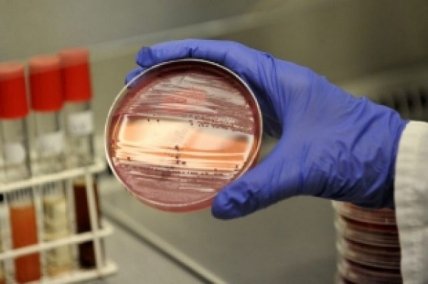

Кишечная инфекция: симптомы и лечение у детей
- Автор
- Дата публикации
- Автор


Кишечная инфекциия - группа инфекционных заболеваний, вызванные различными микроорганизмами, которые в первую очередь нарушают работу пищеварительного тракта. Какие же симптомы и стоит ли лечить кишечную инфекцию в домашних условиях, расказала Анна Шевелева, врач-педиатр и мама двоих детей.
Острые кишечные инфекции у детей могут быть вызваны вирусами, бактериями, паразитами либо грибковой инфекцией. Для них характерен фекально-оральный механизм передачи - с грязными руками или загрязненной пищей («болезнь грязных рук») и поражение пищеварительной системы.
Основные симптомы кишечной инфекции у ребенка
Понос
Рвота
Температура
Из-за потери жидкости при поносе и рвоте происходит обезвоживание. Заболевание сопровождается интоксикацией – слабостью, вялостью, сниженным аппетитом.
Кишечная инфекция у детей. Лечение
Борьба с обезвоживанием. После каждого случая поноса ребенок младше 2-х лет должен выпить около 50-100 мл жидкости. Если ребенок старше 2-х лет – 100-200 мл после каждого поноса. После рвоты нужно подождать 10 минут, затем предложить ребенку пить, медленно, маленькими глоточками. Помимо этого нужно предлагать ребенку дополнительное количество питья.
Если ребенок не может пить сам – необходима госпитализация в стационар, постановка капельницы ребенку (врач рассчитывает необходимый объем жидкости в зависимости от возраста, массы тела ребенка, степени обезвоживания).
Для лечения кишечной инфекции применяют следующие группы препаратов:
- Сорбенты(способствуют выведению токсинов из организма);
- Жаропонижающие (при температуре выше 38-38,5˚С);
- Кишечные антисептики(препараты, которые убивают инфекцию в кишечнике, но при этом не попадают в кровь и не влияют на весь организм);
- Пробиотики (способствуют восстановлению нормальной микрофлоры кишечника);
Антибиотик при кишечной инфекции у детей назначается не всегда, а только в тех случаях, когда:

кишечная инфекция вызвана бактериями (шигелез, холера, кампилобактериоз, амебиаз и др.). И даже при подозрении на это.

при тяжелом течении инфекции, когда в кале появляется кровь, гной (по результатам копрограммы – нейтрофилы в кале, гемоколит).

детям до 3-х месяцев;

если ребенок находится на химиотерапии или гормональной терапии, которые ослабляют иммунитет. А так же при иммунодефиците, вызванном другими причинами (ВИЧ-инфекция или первичный иммунодефицит).

детям с хроническими заболеваниями кишечника, онко-, гематологическими заболеваниями.
Профилактика кишечных инфекций у детей
Главное правило профилактики кишечных инфекций у детей – соблюдение правил гигиены.
- Научите ребенка мыть руки перед едой.
- Всегда мойте сырые овощи и фрукты перед едой. Научите ребенка не есть ягоды с грядки, не пробовать немытые ягоды и фрукты у бабушек на базаре.
- Кормите ребенка качественной, свежеприготовленной пищей.
- Если в доме есть заболевший – изолируйте от него ребенка.
Здоровья вам! И пусть болезни обходят вас стороной.
